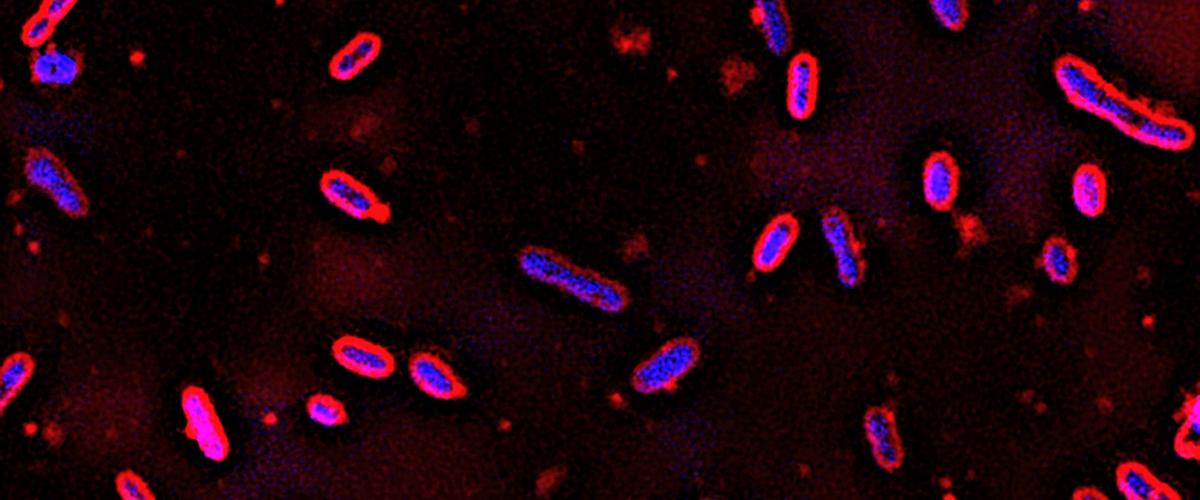
TODO:

Побочный продукт переработки древесины — полимер лигнин, компонент клеточных стенок растений. У этого соединения почти нет полезных применений, и обычно его просто сжигают или складируют. Исследователи из Висконскинского университета в Мадисоне, о работе которых рассказывает Science Daily, нашли способ превратить лигнин в гораздо более ценный материал.
В этом им помогла бактерия Novosphingobium aromaticivorans, которая процветает в почвах, загрязненных нефтепродуктами.
Секрет успеха этого микроорганизма — умение переваривать сложные ароматические соединения, содержащиеся в нефти. Как показали эксперименты, Novosphingobium растет и на лигнине, разлагая его сложную молекулу на более простые ароматические углеводороды.
В отличие от других бактерий, разлагающих лигнин, этот вид переваривает широкий спектр ароматических соединений. Все они на определенном этапе преобразуются в 2-пирон-4,6-дикарбоновую кислоту. Заменив три гена в геноме «диких» Novosphingobium, ученые превратили этот промежуточный продукт в конечный.

Таким образом, ГМО-бактерии стали фабриками по производству 2-пирон-4,6-дикарбоновой кислоты на основе лигнина.
Эта кислота — перспективный материал для производства различных материалов, в том числе биоразлагаемой замены пластика.
Ранее похожую разработку представили исследователи из Великобритании. Однако они использовали другой вид бактерий — Rhodococcus jostii.